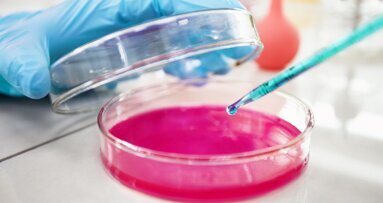
Diptool – polskie narzędzie do szybkiej identyfikacji nowych leków antybakteryjnych

Statystyczny Polak przyjmuje leki przeciwbólowe 7 razy w miesiącu, tymczasem nadużywanie leków i suplementów może opóźnić zdiagnozowanie poważnych chorób – przestrzegają specjaliści. Uniwersytet Śląski wraz z partnerami zainaugurował kampanię społeczną pod hasłem: „Granatem w (prze)dawkowanie. UŚwiadamiamy”, która ma uświadomić zagrożenia z tym związane.
„Angażujemy się w szerokim zakresie w to, co firmy nazywają społeczną odpowiedzialnością biznesu, my zaś nazywamy nową społeczną odpowiedzialnością uniwersytetu” – powiedział prof. Wiesław Banyś. Jak podkreślają specjaliści, przyjmowanie leków dostępnych bez recepty i bez konsultacji z lekarzem staje się coraz bardziej powszechne. W ciągu ostatnich kilkunastu lat popyt na leki w Polsce wzrósł 4-krotnie. Samodzielna terapia dolegliwości bólowych staje się powszechnie występującym zjawiskiem w polskim społeczeństwie. Dodatkowo reklamy umacniają przekonanie, że każdy problem zdrowotny można rozwiązać za pomocą „magicznej pigułki”. W ten sposób kształtuje się u odbiorcy odruch: „Coś ci dolega? Zażyj tabletkę. Nic ci nie jest? Zażyj profilaktycznie”.
„Suplementy to bardzo duży problem. Pacjenci nie diagnozują przyczyn swoich dolegliwości, tylko uciekają w leczenie, które ma je zmniejszyć. To nie jest dobre postępowanie z punktu widzenia medycznego. Dobre jest takie: zdiagnozuj się, poszukaj przyczyny bólu, a następnie zastosuj leczenie i być może – jeśli masz niedobory witamin czy minerałów, to je zastosuj” – tłumaczy farmakolog kliniczny doc. Paweł Madej, który kieruje Oddziałem Chorób Wewnętrznych z Pododdziałami: Diagnostyki Kardiologicznej oraz Diabetologii Szpitala Zakonu Bonifratrów pw. Aniołów Stróżów w Katowicach. Podkreśla, że suplement może opóźnić rozpoznanie bardzo poważnych chorób, np. suplementacja żelaza u mężczyzny może opóźnić zdiagnozowanie nowotworu układu pokarmowego. Zwraca też uwagę na groźne interakcje leków, np. preparaty przeciwbólowe mogą zniwelować efekt działania leków przyjmowanych w przypadku nadciśnienia tętniczego.
„Pacjenci sięgają po leki natychmiast, kiedy pojawia się ból albo nawet, kiedy bólu jeszcze nie ma – 6% przewiduje pojawienie bólu i zażywa tabletki, 40% zażywa tabletki przy pierwszych objawach bólu, a być może wystarczyłaby filiżanka herbaty. Ból głowy może być spowodowany przez źle dobrane okulary albo z powodu takich chorób, jak: jaskra, problemy z zatokami czy nadciśnienie, 30% Polaków nie wie, że ma nadciśnienie tętnicze” – mówił doc. Madej.
Kampanię współorganizują Uniwersytet Śląski, Szpital Zakonu Bonifratrów pw. Aniołów Stróżów w Katowicach oraz CenterMed. Oprócz uświadomienia zagrożeń związanych z nadużywaniem leków przeciwbólowych i suplementów, dostarczy ona informacji o alternatywnych metodach radzenia sobie z bólem, a także o sposobach dbania o zdrowie na co dzień. Informacje można znaleźć na stronie internetowej kampanii www.us.edu.pl.
Źródło: PAP - Nauka w Polsce
Zgodnie z projektem Rozporządzenia Ministra Zdrowia w sprawie kryteriów klasyfikacji produktów leczniczych, które mogą być ...
Zdrowe, niskotłuszczowe przekąski zawierają ponad 69% cukru – to ponad 3 razy więcej niż np. w lodach czekoladowych. Nie wszyscy wiedzą, że ...
Wolne cukry (FS) to cukry dodawane do żywności podczas jej produkcji, a także cukry naturalnie obecne w miodzie, syropach i sokach owocowych. Termin ten ...
Jeśli wydatki państwa na dopłaty do leków zostaną ograniczone, dla 1/3 Polaków zrealizowanie recepty będzie oznaczać rezygnację z ...
W czasach, gdy odporność bakterii na antybiotyki stanowi globalne wyzwanie zdrowotne, naukowcy poszukują nowych sposobów zwalczania mikroorganizmów. Dr...
Najnowsze badanie opinii „Polacy o zdrowym stylu życia”, mające na celu pokazanie tego, jak mieszkańcy naszego kraju definiują zdrowy styl ...
Wg raportu pt.: „Rynek prywatnej opieki zdrowotnej w Polsce 2012. Prognozy rozwoju na lata 2012-2014”, w 2011 r. wartość rynku prywatnej ...
Autorzy przedstawiają przypadek wyrośla kostnego szczęki zlokalizowanego w obrębie wyrostka zębodołowego. Zmiana znacznych rozmiarów została ...
Spośród wielu sposobów finansowania zakupu samochodów firmowych, największym powodzeniem wśród mikro-, małych i średnich ...
Spośród wielu sposobów finansowania zakupu samochodów firmowych, największym powodzeniem wśród mikro-, małych i średnich ...
Webinarium na żywo
pon. 8 czerwca 2026
6:00 (CET) Warsaw
Webinarium na żywo
pon. 8 czerwca 2026
7:00 (CET) Warsaw
Dr. Anthony Mak B.D.S, Prof. Marleen Peumans
Webinarium na żywo
pon. 8 czerwca 2026
8:00 (CET) Warsaw
Webinarium na żywo
śro. 10 czerwca 2026
5:00 (CET) Warsaw
Webinarium na żywo
śro. 10 czerwca 2026
8:00 (CET) Warsaw
Nacho Fernández-Baca DDS, MSc
Webinarium na żywo
czw. 11 czerwca 2026
1:00 (CET) Warsaw
Webinarium na żywo
czw. 11 czerwca 2026
7:00 (CET) Warsaw



 Austria / Österreich
Austria / Österreich
 Bośnia i Hercegowina / Босна и Херцеговина
Bośnia i Hercegowina / Босна и Херцеговина
 Bułgaria / България
Bułgaria / България
 Chorwacja / Hrvatska
Chorwacja / Hrvatska
 Czechy i Słowacja / Česká republika & Slovensko
Czechy i Słowacja / Česká republika & Slovensko
 Francja / France
Francja / France
 Niemcy / Deutschland
Niemcy / Deutschland
 Grecja / ΕΛΛΑΔΑ
Grecja / ΕΛΛΑΔΑ
 Węgry / Hungary
Węgry / Hungary
 Włochy / Italia
Włochy / Italia
 Holandia / Nederland
Holandia / Nederland
 nordycki / Nordic
nordycki / Nordic
 Polska / Polska
Polska / Polska
 Portugalia / Portugal
Portugalia / Portugal
 Rumunia i Mołdawia / România & Moldova
Rumunia i Mołdawia / România & Moldova
 Słowenia / Slovenija
Słowenia / Slovenija
 Serbia i Czarnogóra / Србија и Црна Гора
Serbia i Czarnogóra / Србија и Црна Гора
 Hiszpania / España
Hiszpania / España
 Szwajcaria / Schweiz
Szwajcaria / Schweiz
 indyk / Türkiye
indyk / Türkiye
 Wielka Brytania i Irlandia / UK & Ireland
Wielka Brytania i Irlandia / UK & Ireland
 Międzynarodowy / International
Międzynarodowy / International
 Brazylia / Brasil
Brazylia / Brasil
 Kanada / Canada
Kanada / Canada
 Ameryka Łacińska / Latinoamérica
Ameryka Łacińska / Latinoamérica
 USA / USA
USA / USA
 Chiny / 中国
Chiny / 中国
 Indie / भारत गणराज्य
Indie / भारत गणराज्य
 Pakistan / Pākistān
Pakistan / Pākistān
 Wietnam / Việt Nam
Wietnam / Việt Nam
 ASEAN / ASEAN
ASEAN / ASEAN
 Izrael / מְדִינַת יִשְׂרָאֵל
Izrael / מְדִינַת יִשְׂרָאֵל
 Algieria, Maroko i Tunezja / الجزائر والمغرب وتونس
Algieria, Maroko i Tunezja / الجزائر والمغرب وتونس
 Bliski Wschód / Middle East
Bliski Wschód / Middle East

To post a reply please login or register